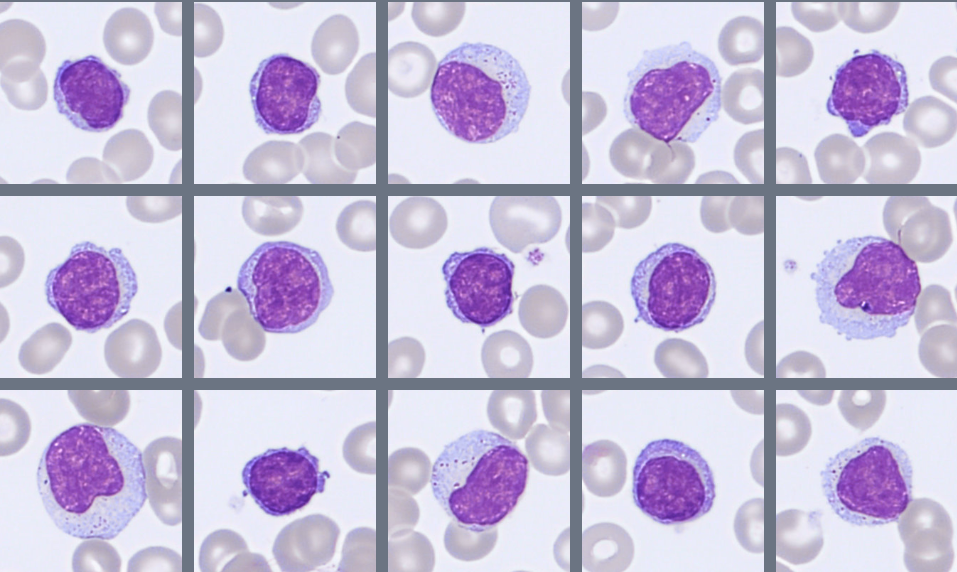
Lymphocytes Monthly Cell Challenge April 2026
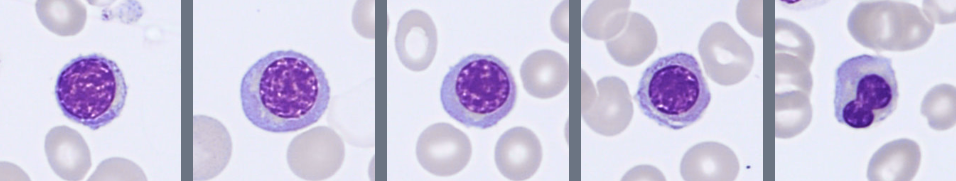
NRBC Monthly Cell Challenge April 2026

Monthly Cell Challenge #04 / 2026

Signals from the Marrow
A 72-year-old man was referred to his primary care physician because of gradually increasing fatigue and reduced stamina over the past several months. He reported that activities that previously caused no difficulty now left him feeling unusually tired.
The patient denied fever, night sweats, or recent infections. He had not experienced significant weight loss or bleeding symptoms. His medical history included hypertension and hyperlipidemia, both treated with medication.
On physical examination, the patient appeared mildly pale but was otherwise in stable condition. No lymphadenopathy was detected, and there was no clinically apparent hepatosplenomegaly.
As part of the clinical evaluation, blood samples were obtained for routine laboratory testing.
CBC results:
| Test | Result | Units |
|---|---|---|
| WBC | 14.2 | x109/L |
| RBC | 2.7 | 1012/L |
| HGB | 86 | g/L |
| MCV | 96 | fL |
| PLT | 42 | x109/L |
Blood smear analysis classification on CellaVision DC-1
| WBC Differential | % | x109/L |
|---|---|---|
| Neutrophils | 31 | 4.4 |
| Lymphocytes | 25.5 | 3.6 |
| Monocytes | 7.5 | 1.1 |
| Promyelocytes | 0.5 | 0.1 |
| Myelocytes | 3.5 | 0.5 |
| Metamyelocytes | 4.0 | 0.6 |
| Blasts | 28 | 4.0 |
| NRBC | 5/100 WBCs | |
Blood smear findings:

Microscopic examination of the peripheral blood smear reveals several abnormalities involving multiple hematopoietic cell lineages.
Approximately 28% blast cells are present among circulating leukocytes. The blasts are medium-sized cells with a high nuclear-to-cytoplasmic ratio, round to slightly irregular nuclei, fine chromatin, and visible nucleoli. The cytoplasm is moderately basophilic and mostly agranular, although occasional cells contain fine azurophilic granules. Auer rods are not observed.
The granulocytic lineage shows dysplastic features, including hypogranulation and hypersegmented neutrophils. Circulating immature granulocytes are also present, including promyelocytes, myelocytes, and metamyelocytes.
Monocytes are moderately increased and display variable maturation, ranging from less mature forms to cells with folded nuclei and grey-blue cytoplasm, sometimes containing fine vacuoles.
Overall, the smear demonstrates a significant blast population together with dysplastic changes in several cell lineages, prompting further evaluation with bone marrow examination.
Bone marrow aspirate findings:



The bone marrow appears hypercellular, with an increased number of blast cells representing approximately 25% of nucleated cells. The blasts are medium to large cells with a high nuclear-to-cytoplasmic ratio, fine chromatin, and visible nucleoli. The cytoplasm is moderately basophilic and mostly agranular, with occasional fine azurophilic granules. Auer rods are not seen.
Residual hematopoiesis shows morphological abnormalities in several cell lineages. Granulopoiesis demonstrates abnormal nuclear segmentation and reduced granulation.
Immunophenotyping
Flow cytometric analysis of the bone marrow demonstrates a blast population representing approximately 20% of nucleated cells. The blasts express CD34, CD13, CD33, CD117, and weak MPO, with partial HLA-DR expression, consistent with immature myeloid cells. No aberrant lymphoid populations are identified.
Diagnosis:
Acute Myeloid Leukemia with myelodysplasia-related changes (AML-MR), WHO 2024.
Discussion:
Acute myeloid leukemia (AML) is a clonal hematopoietic malignancy characterized by the proliferation of immature myeloid precursor cells (blasts) in the bone marrow and peripheral blood. The accumulation of blasts interferes with normal hematopoiesis and results in cytopenias due to reduced production of mature blood cells [1]. According to the WHO Classification of Haematolymphoid Tumours (5th edition, 2024), AML is generally defined by the presence of ≥20% blasts in the bone marrow or peripheral blood, unless specific genetic abnormalities establish the diagnosis independently of blast percentage [1].
AML mainly affects older adults, with a median age at diagnosis of approximately 65–70 years [2]. Clinical symptoms often reflect bone marrow failure. Patients commonly present with fatigue caused by anemia, increased susceptibility to infections due to neutropenia, and bleeding or bruising related to thrombocytopenia [2,3].
In some patients, AML develops from a pre-existing myelodysplastic syndrome (MDS) or shows morphological and genetic features associated with MDS. In the WHO classification, such cases are categorized as AML with myelodysplasia-related changes (AML-MR) [1]. MDS is characterized by ineffective hematopoiesis and dysplasia affecting one or more hematopoietic lineages. As the disease evolves, additional genetic abnormalities may accumulate, leading to clonal progression and transformation to AML. This transformation occurs in approximately 20–30% of patients, depending on the subtype and risk category of the underlying MDS [4].
Morphologically, AML is typically characterized by the presence of blast cells with a high nuclear-to-cytoplasmic ratio, fine chromatin, and visible nucleoli. In cases associated with MDS, dysplastic changes may also be present in other hematopoietic lineages, including hypogranulated neutrophils, abnormal nuclear segmentation, dysplastic erythroid precursors, and atypical megakaryocytes [2].
Morphological examination remains an essential first step in the evaluation of suspected hematologic malignancies. In this case, abnormal circulating cells were initially detected during digital review using the CellaVision® Peripheral Blood Application, which prompted further investigation. Bone marrow evaluation was then performed using the CellaVision® Bone Marrow Aspirate Application, allowing systematic review of bone marrow aspirate smears and assessment of hematopoietic precursors at different stages of maturation. Together, CellaVision® digital morphology solutions support efficient identification and classification of abnormal cells in both peripheral blood and bone marrow specimens.
Morphology often provides the first clues to a hematologic malignancy, but additional investigations are required to confirm the diagnosis. Flow cytometry helps determine the lineage and maturation stage of blast cells, while cytogenetic and molecular analyses identify genetic abnormalities that are important for disease classification, prognosis, and treatment decisions [1,2].
Treatment of AML depends on several factors, including patient age, overall health, and genetic risk profile. Treatment options may include intensive chemotherapy, hypomethylating agents, targeted therapies, or allogeneic stem cell transplantation in selected patients [3]. Despite advances in treatment, AML remains a serious disease, particularly in older patients. Overall five-year survival is approximately 25–30%, although outcomes vary depending on cytogenetic and molecular risk factors [3].
This case highlights the importance of careful morphological assessment and illustrates how digital morphology tools can support the recognition of abnormal hematopoietic cells during routine laboratory evaluation.
References:
[1] WHO Classification of Tumours Editorial Board. WHO classification of tumours Haematolymphoid tumours. 5th ed. Lyon: International Agency for Research on Cancer; 2024.
[2] Bain BJ. Blood cells: a practical guide. 6th ed. Oxford: Wiley-Blackwell; 2020.
[3] Rodak BF, Fritsma GA, Keohane EM. Rodak's hematology: clinical principles and applications. 6th ed. St. Louis: Elsevier; 2020.
[4] Döhner H, Wei AH, Appelbaum FR, Craddock C, DiNardo CD, Dombret H, et al. Diagnosis and management of AML in adults: 2022 recommendations from an international expert panel. Blood. 2022;140(12):1345–1377.